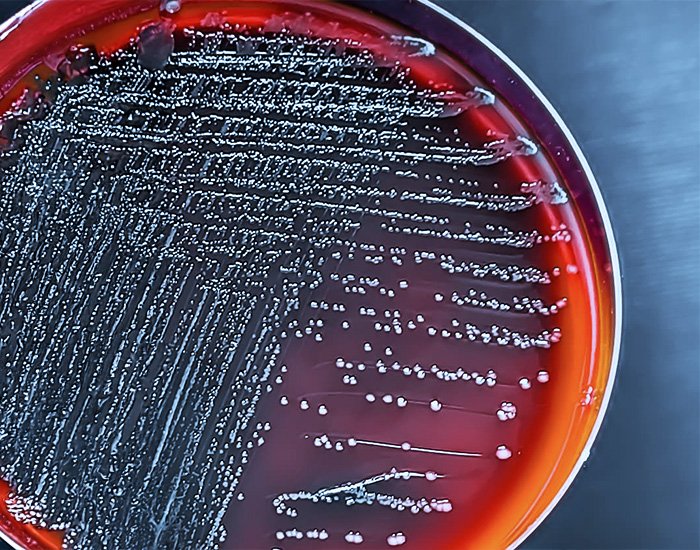

40 anos de excelência em saúde
Exames laboratoriais com qualidade e agilidade
Laboratório de análises clínicas de confiança em Angra dos Reis, Paraty e Niterói. Tecnologia avançada, atendimento humanizado e resultados precisos.


Mais de 40 anos comprometidos com o atendimento que você merece.
Descobertas para mudar vidas.
Desde 1985, o Angralab é o laboratório de exames em Angra dos Reis referência em análises clínicas na região. Ao longo de 40 anos, construímos uma história baseada em três pilares fundamentais: precisão técnica, tecnologia de ponta e cuidado humanizado.
Nosso compromisso é oferecer resultados confiáveis com o atendimento que você merece. Mais que exames, entregamos tranquilidade e cuidado em cada etapa da sua jornada de saúde.
-
Precisão e rastreabilidade em todo o processo.
-
Atendimento humanizado e acolhedor.
-
Rapidez na liberação de resultados.
Exames e serviços que facilitam sua vida
Check-up Completo
Economia com pacotes personalizados para diferentes perfis e faixas etárias.
Pré-Atendimento
Evite filas! Envie sua guia com antecedência via WhatsApp e chegue com tudo pronto.
Coleta Domiciliar
Realize seus exames sem sair de casa. Vamos até você com todo o cuidado e segurança.
Portal de Resultados
Acesse seus laudos online de forma segura, a qualquer hora e de qualquer lugar.
Experiências que inspiram crescimento
Desde 1985 cuidando da saúde de milhares de famílias com compromisso e excelência. Nosso time é treinado para acolher você com respeito, empatia e atenção em cada visita.
Exames completos para toda a família
Realizamos mais de 1000 tipos de exames com tecnologia de ponta

01.
Exames de Rotina
→ Hemograma Completo
→ Glicose
→ Colesterol Total e Frações
→ TSH (Tireoide)
→ Vitamina D
→ Ácido Úrico
→ Ureia e Creatinina
→ EAS (Urina)

02.
Saúde da Mulher
→ Beta-HCG (Gravidez)
→ Hormônios Femininos
→ Papanicolau
→ Estradiol
→ Progesterona
→ Prolactina

03.
Saúde do Homem
→ PSA (Próstata)
→ Testosterona
→ Check-up Masculino
→ FSH
→ LH
04.
Exames Especiais
→ COVID-19 → (PCR/Antígeno)
→ Teste de Paternidade
→ Toxicológico (CNH)
→ Teste do Pezinho
→ Alergias (IgE Específico)

Check-ups pensados para cada fase da vida
Check-up Kids
Acompanhe o desenvolvimento saudável do seu filho
Check-up Homem
Exames essenciais para a saúde masculina
Check-up Mulher
Cuidado feminino em todas as fases da vida
Check-up 3ª Idade
Acompanhamento especial para +60 anos
10.0
NPS MÉDIO
Nível máximo de satisfação dos nossos clientes.
Avaliação dos clientes
Uma experiência recomendada por quem confia no AngraLab.
Nosso NPS mede a satisfação dos clientes e a probabilidade de recomendarem o AngraLab para outras pessoas.
-
Atendimento humanizado
-
Confiança em todo o processo
-
Confiança em todo o processo
